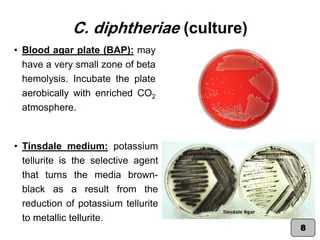
Corynebacterium spp. & Listeria monocytogenes (Practical Medical Micr&hellip;

11 Listeria monocytogenes 在 Tinsdale’s agar 中培養,其菌落應呈現何種顏色?
(A)無色菌落
(B)黑色菌落
(C)紅色菌落周圍具有棕色暈環(brown halo)
(D)綠色菌落
答案:登入後查看
統計: A(118), B(396), C(325), D(14), E(0) #672014
統計: A(118), B(396), C(325), D(14), E(0) #672014
詳解 (共 5 筆)
#1315411
Tinsdale瓊脂用於白喉桿菌的主要分離和鑑定。白喉桿菌,並在上呼吸道和有時在皮膚中發現的類白喉之間的介質區分。這種差異是基於白喉棒狀桿菌的產生灰黑色菌落的能力,用棕/黑暈包圍。白喉不具備這種能力
13
5
#1057467
Tinsdale Agar is used for the primary isolation and identification of Corynebacterium diptheriae.
The medium differentiates between C. diphtheriae and the diphtheroids found in the upper respiratory tract and
sometimes on the skin. This differentiation was based on the ability of C. diphtheriae to produce greyish-black
colonies, surrounded by a brown/black halo. Diphtheroids do not have this ability
7
2
#5704645
0
0
#5974524
白侯有brown halo
李斯特菌沒有
0
0